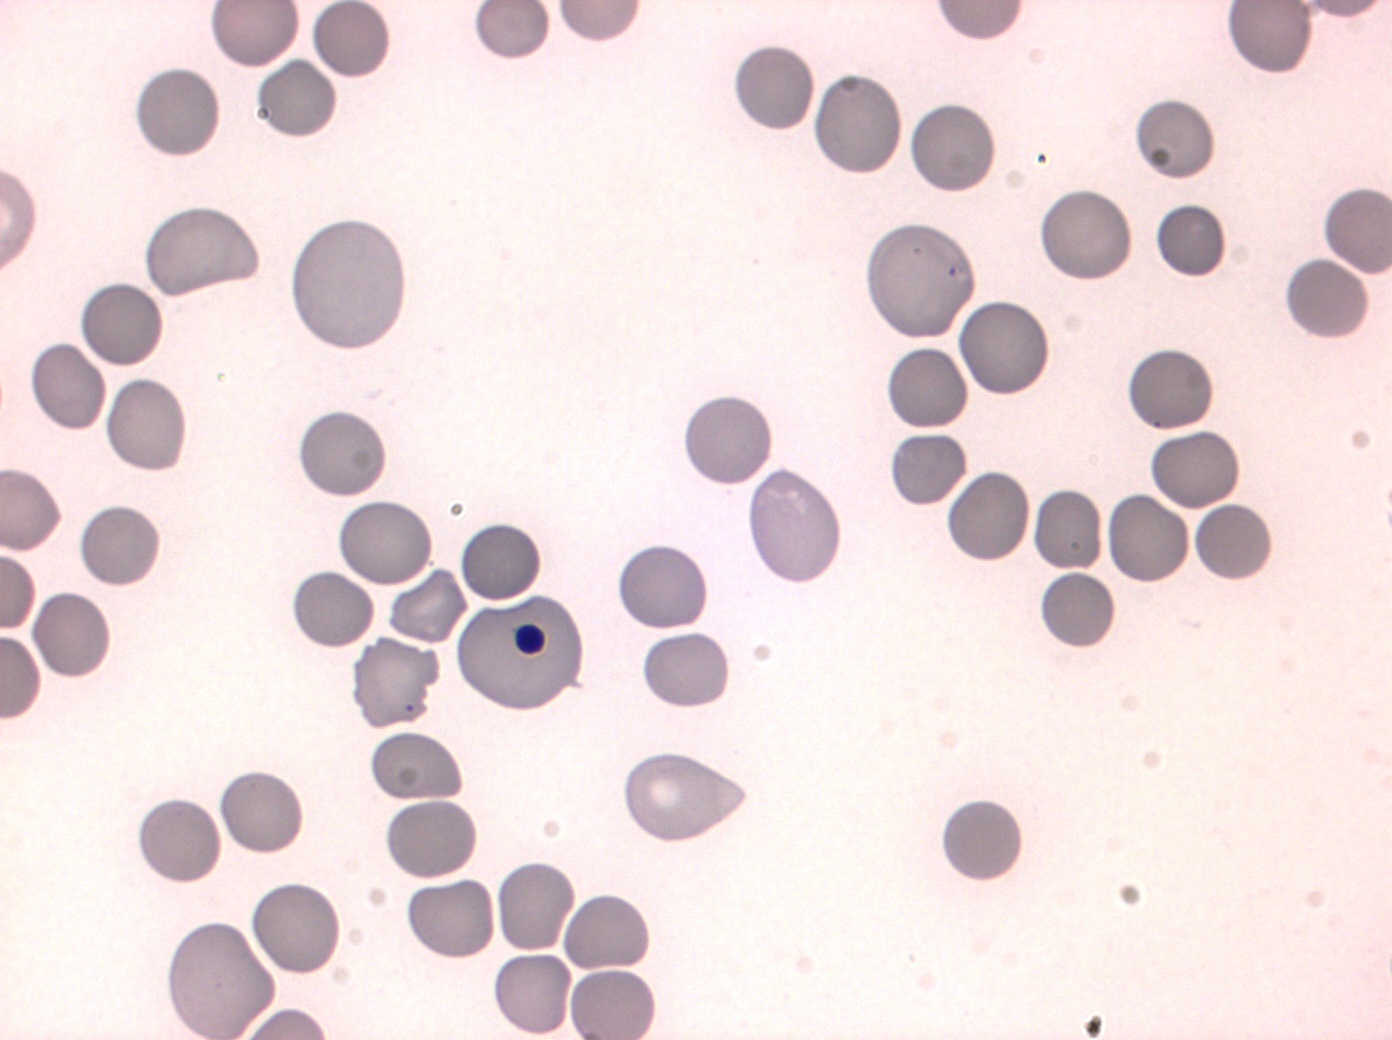
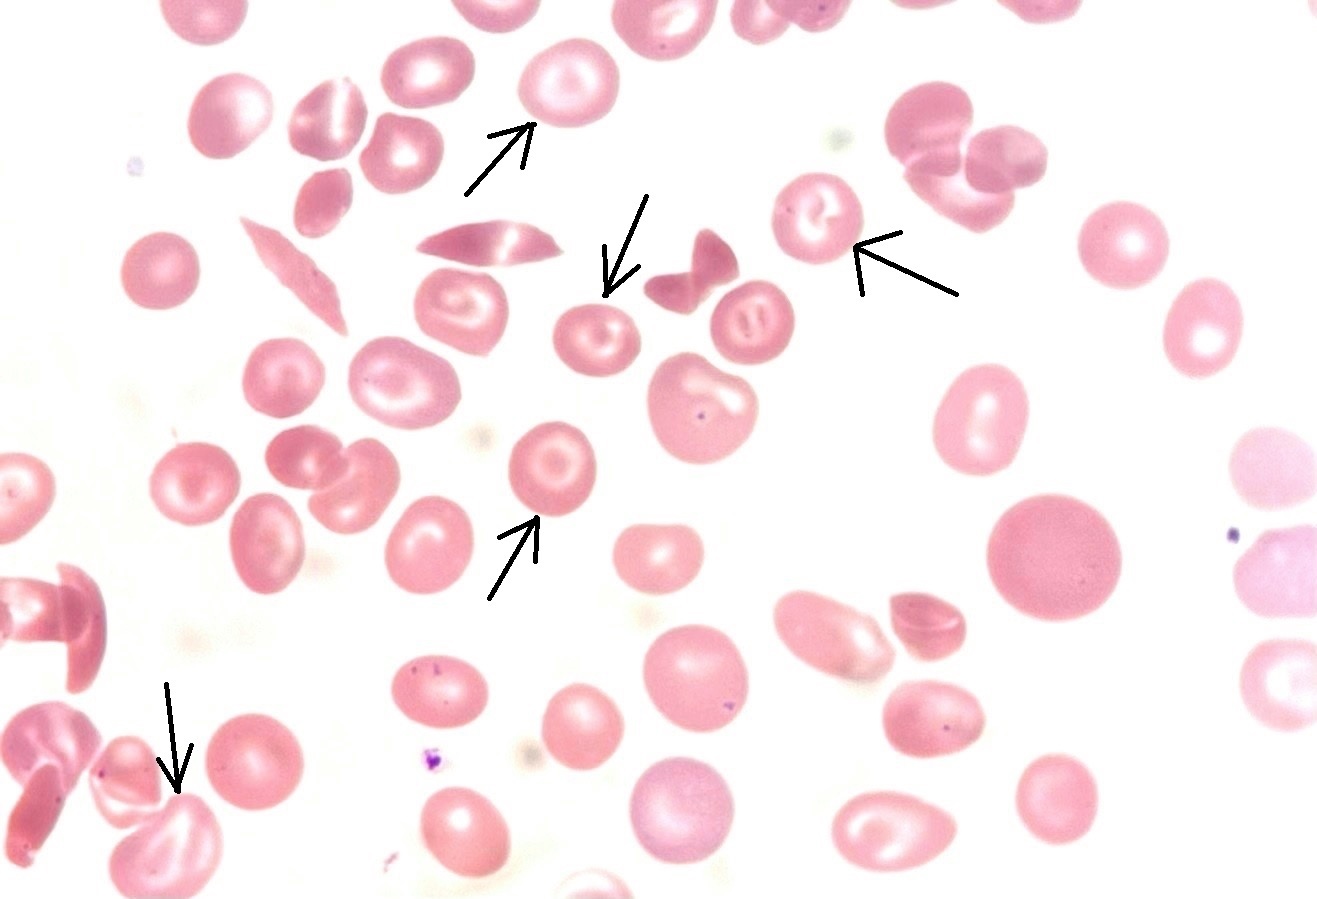
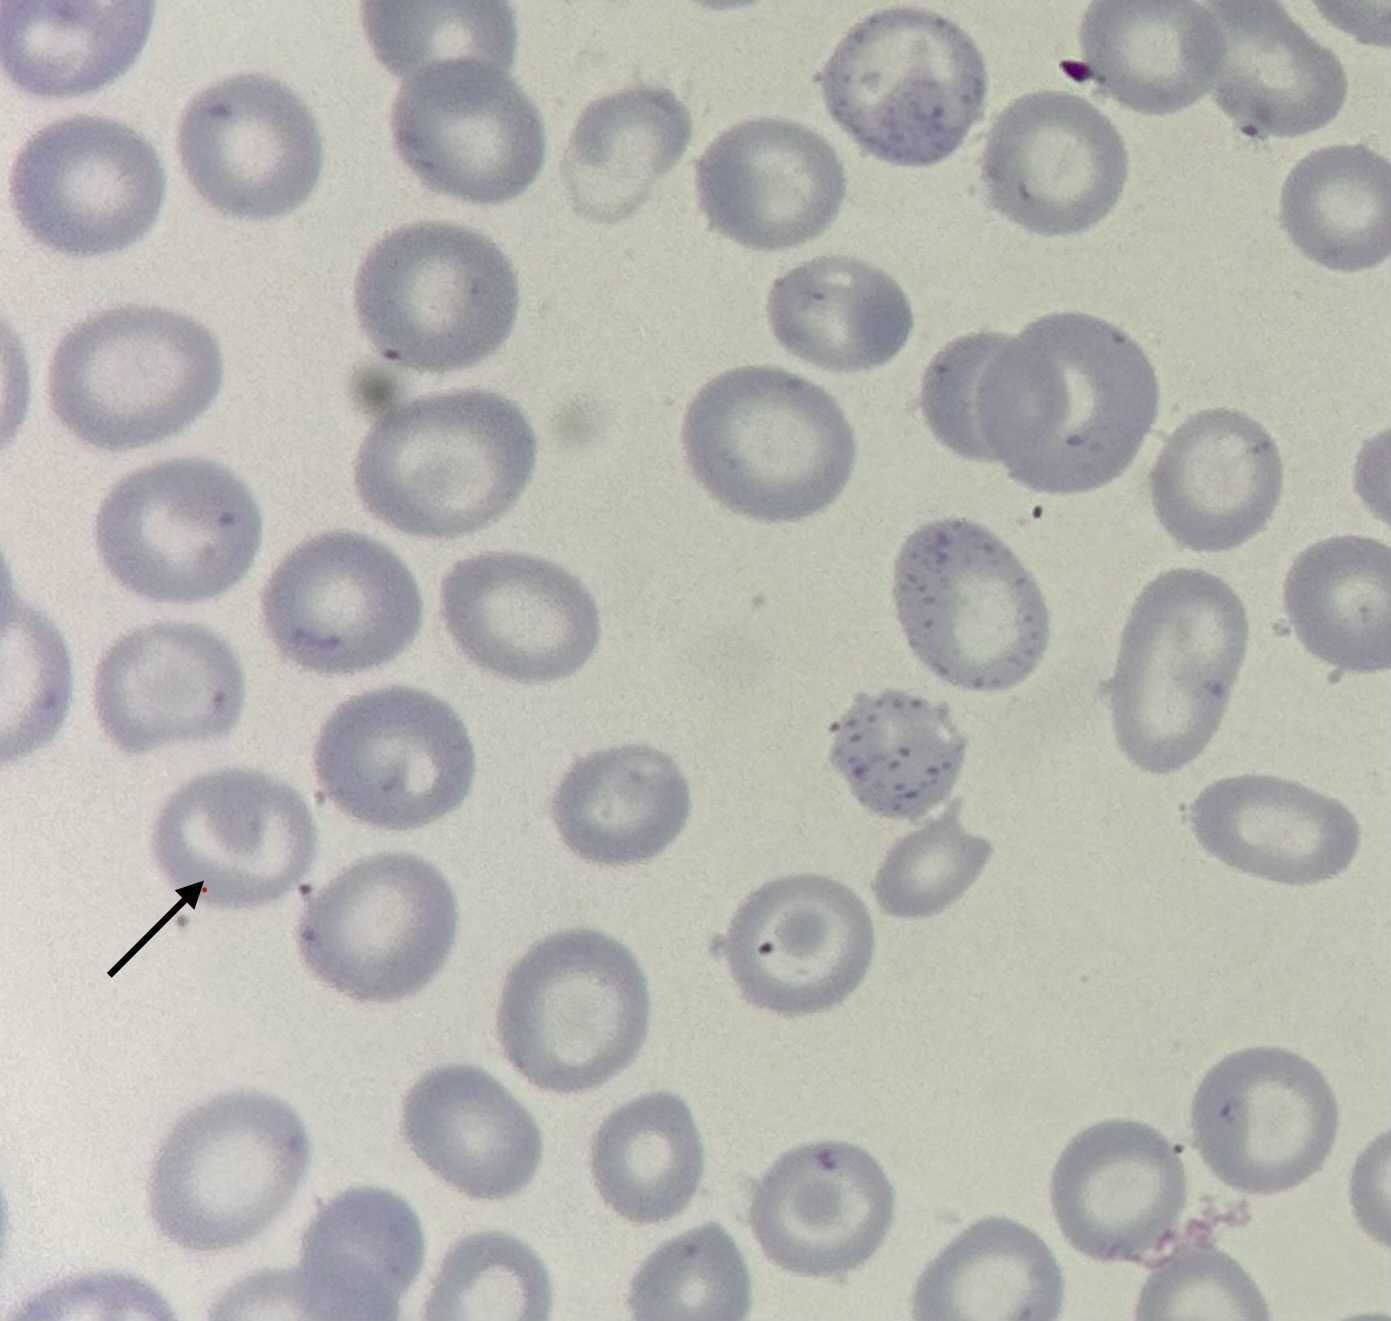
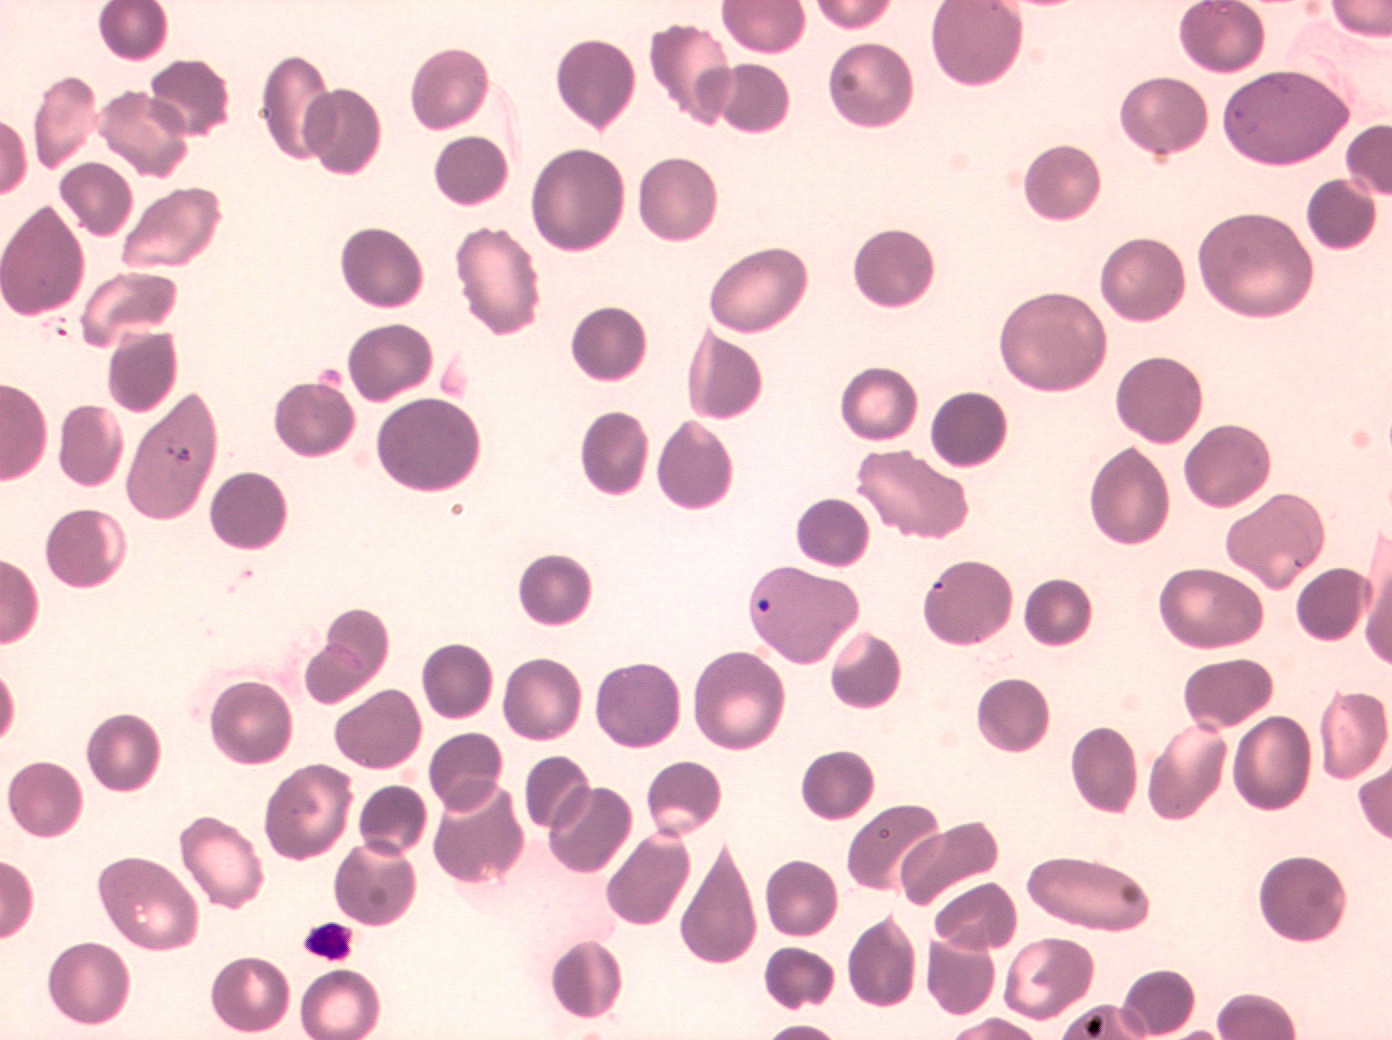
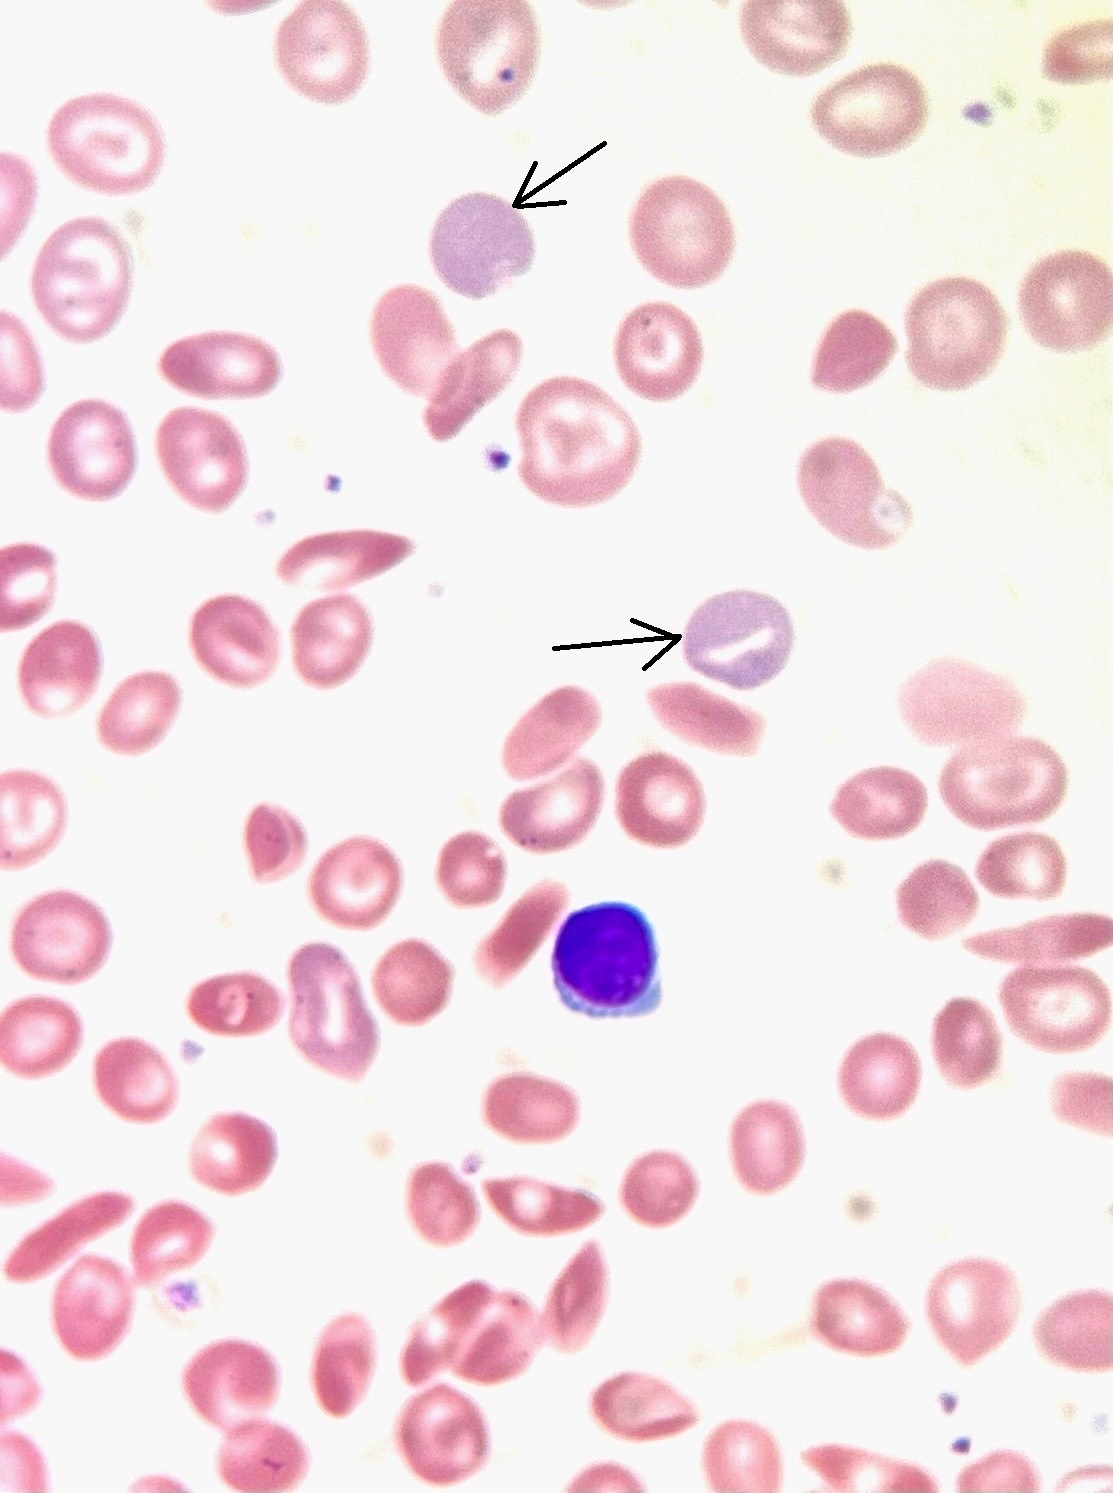
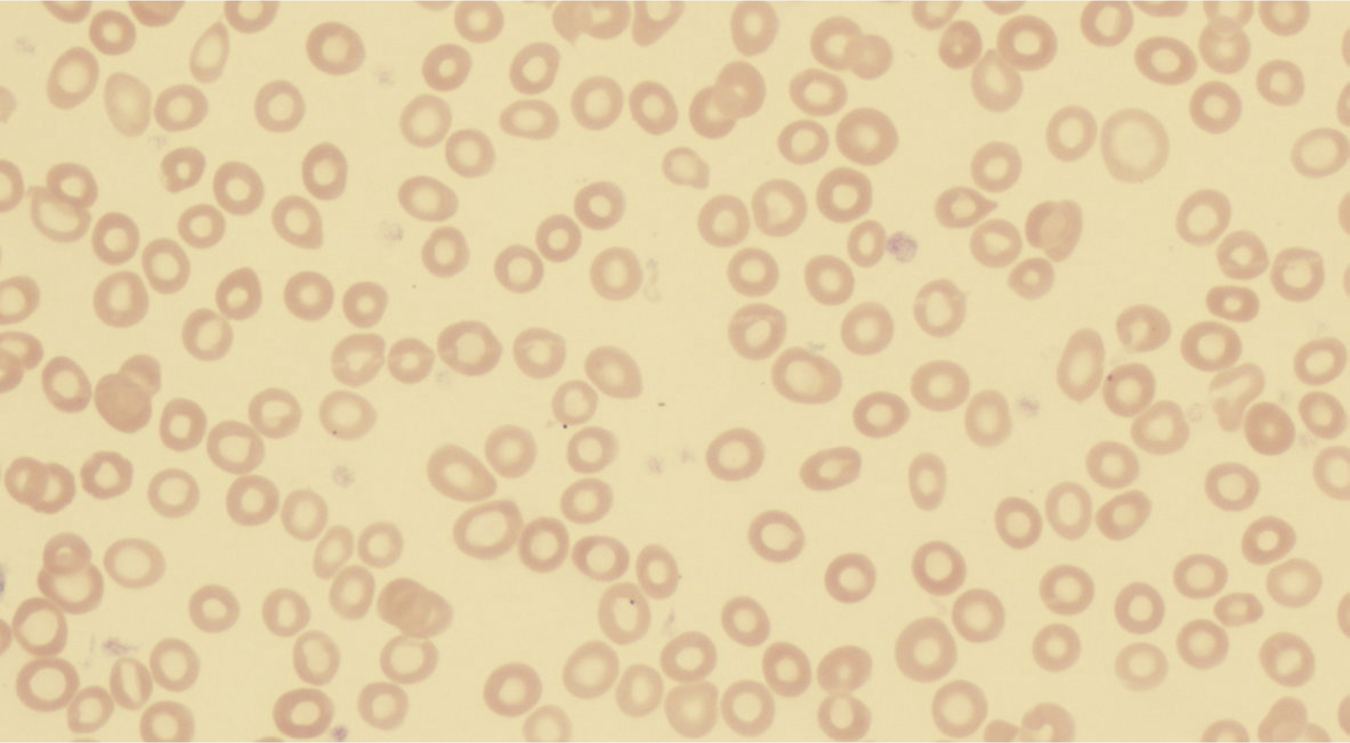

Склеенные эритроциты
Склеенные эритроциты 101 фотографий
Бессмертник календула
Корзинка с белыми цветами
Отвела душу что значит
Отключается интернет каждые 5 минут
Форум китайский автомобиль отзывы
Елецкая лебедянская епархия
Дрон для опрыскивания полей
Орифлейм крем оптималс
Комбинированный серые шторы
Полотно композитное